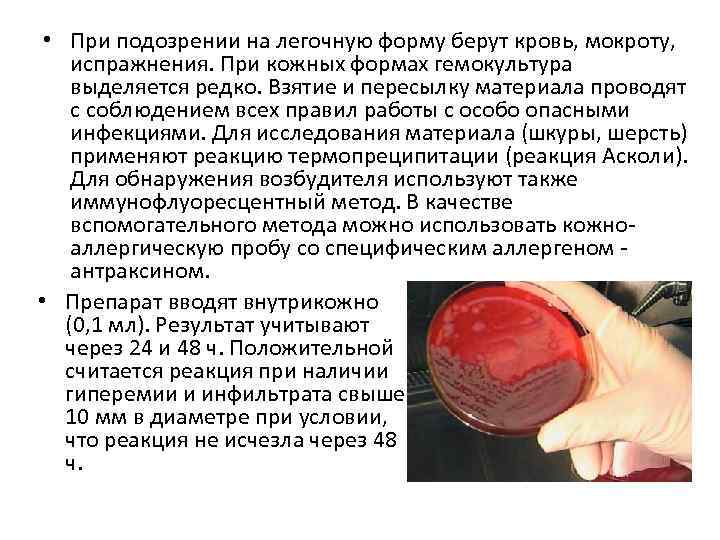
• При подозрении на легочную форму берут кровь, мокроту, испражнения. При кожных формах

Сибирская язва11.pptx
- Количество слайдов: 26

Сибирская язва Выполнили: студентки 6 группы 6 курса лечебного факультета Сиротина Е. Э. Щербакова Е. И.

• Сибирская язва (злокачественный карбункул; Anrhrax; болезнь тряпичников; болезнь сортировщиков шерсти) особоопасная острая, сапрозоонозная, бактериальная инфекция с контактным механизмом передачи и характеризующаяся серозногеморрагическим воспалением кожи и других органов на фоне интоксикации.

History… • Заболевание известно с древних времён под названием «священный огонь» , «персидский огонь» и др. В дореволюционной России, ввиду преимущественного распространения в Сибири, оно получило название сибирской язвы. Значительную роль в этом названии сыграл российский учёный С. С. Андреевский, самозаражением доказавший идентичность сибирской язвы человека и животного, а также указавший на возможность передачи её от животных к человеку. Не переживайте, Андреевский вылечился

Реальность биотерроризма • Разнообразие мотивировок для проведения террористических актов или уголовных преступлений с использованием биологических агентов подробно описано в базе данных, созданной в Институте международных исследований Монтере (Monterey), США. С 1900 по 1999 г. на основании открытых источников было зафиксировано 415 случаев использования или попыток использования биологических, химических и ядерных материалов в уголовных, политических или идеологических целях. Диапазон мотивов чрезвычайно широк: от личной мести до попытки уничтожить основную часть человечества, чтобы вывести из оставшейся части новую расу. Практически во всех случаях у исполнителей обнаруживали психические отклонения.

• В целом анализ попыток применения биологических агентов для криминальных или террористических целей свидетельствует об их относительной редкости. Число пострадавших от биологического терроризма ничтожно мало в сравнении числом пострадавших от "традиционных" видов терроризма. Однако эти соображения ни в коем случае не могут служить основанием для оптимизма, поскольку биологические агенты приобрели все характеристики оружия массового поражения.

Этиология. • Возбудитель - Bacillus anthracis представляет собой довольно крупную палочку длиной 6 -10 мкм и шириной 1 -2 мкм. Она неподвижная, окрашивается по Граму, образует споры и капсулу. Хорошо растет на различных питательных средах. Вегетативные формы быстро погибают без доступа воздуха, при прогревании, под воздействием различных дезинфицирующих средств. Споры сибирской язвы весьма устойчивы во внешней среде, они могут сохраняться в почве до 10 лет и более. Споры образуются вне организма при доступе свободного кислорода. Вирулентность возбудителя обусловлена наличием капсулы и экзотоксина. Помимо пенициллина возбудитель сибирской язвы чувствителен также к антибиотикам тетрациклиновой группы, левомицетину, стрептомицину, неомицину. Возбудитель сибирской язвы

Эпидемиология. • Источник заражения – почва (является естественным резервуаром, поэтому и заболевание называется сапрозоонозом), крупный и мелкий рогатый скот, лошади, верблюды, дикие животные – эти животные выделяют возбудителя со своими биологическими жидкостями. • Пути передачи – контактный (через заражённые предметы быта продуктами жизнедеятельности животных или почвой), алиментарный (через заражённую пищу), воздушно-пылевой (через воздух), трансмиссивный (через эктопаразитов).

В странах Африки допускается возможность передачи инфекции посредством укусов кровососущих насекомых. Заражения человека от человека обычно не наблюдается. Сибирская язва широко распространена во многих странах Азии, Африки и Южной Америки. В США и странах Европы наблюдаются единичные случаи заболеваний сибирской язвой.

Патогенез. • Воротами инфекции чаще служит кожа. Обычно возбудитель внедряется в кожные покровы верхних конечностей (около половины всех случаев) и головы (20 -30%), реже туловища (38%) и ног (1 -2%). В основном поражаются открытые участки кожи. Уже через несколько часов после заражения начинается размножение возбудителя в месте ворот инфекции (в коже). При этом возбудители образуют капсулы и выделяют экзотоксин, который вызывает плотный отек и некроз. Из мест первичного размножения возбудители по лимфатическим сосудам достигают регионарных лимфатических узлов, а в дальнейшем возможно гематогенное распространение микробов по различным органам. При кожной форме в месте первичного воспалительно-некротического очага вторичная бактериальная инфекция особой роли не играет.

• При аэрогенном заражении споры фагоцитируются альвеолярными макрофагами, затем они попадают в медиастенальные лимфатические узлы, где происходит размножение и накопление возбудителя, некротизируются и лимфатические узлы средостения, что приводит к геморрагическому медиастениту и бактериемии. В результате бактериемии возникает вторичная геморрагическая сибиреязвенная пневмония. • При употреблении инфицированного (и недостаточно прогретого) мяса споры проникают в подслизистую оболочку и регионарные лимфатические узлы. Развивается кишечная форма сибирской язвы, при которой возбудители также проникают в кровь и заболевание переходит в септическую форму. Таким образом, септическое течение может возникнуть при любой форме сибирской язвы. В патогенезе сибирской язвы большое значение имеет воздействие токсинов, образуемых возбудителем. Перенесенное заболевание оставляет после себя стойкий иммунитет, хотя и имеются описания повторных заболеваний через 10 -20 лет после первого заболевания.

Клиническая картина • Продолжительность инкубационного периода колеблется от нескольких часов до дней, чаще всего составляет 2— 3 дня. Заболевание может протекать в локализованной (кожной и висцеральной) или генерализованной (септической) форме. • В месте внедрения возбудителя происходит действие токсина и это свидетельствует о начале следующего периода, т. к в этом месте происходит видоизменение тканей. Период клинических проявлений характеризуется острым началом и в зависимости от входных ворот возникает либо кожная, либо генерализованная форма. Но в любом случае, где бы не проник возбудитель, везде будет одинаковый механизм – под действием экзотоксина происходит повреждение эндотелия сосудов, в результате чего нарушается их проницаемость, возникает серозногеморрагический отёк, воспаление, геморрагические инфильтраты и утрата чувствительности в воротах инфекции:

Кожная форма сибирской язвы • Встречается в 98— 99 % всех случаев сибирской язвы. Наиболее частой ее разновидностью является карбункулёзная форма, реже встречаются эдематозная, буллёзная и эризипелоидная формы заболевания. Поражаются преимущественно открытые части тела; особенно тяжело протекает болезнь при локализации карбункулов на голове, шее, слизистых оболочках рта и носа. Кожная форма сибирской язвы при локализации на лице - шее

• Клиника генерализации сибиреязвенной инфекции, вне зависимости от формы — кожной или висцеральной, — при крайнем многообразии проявлений в начальном периоде болезни в терминальной стадии однотипна: она сопровождается выходом в периферическую кровь сибиреязвенных микробов, концентрация которых достигает сотен тысяч и миллионов бактериальных клеток в 1 мм³ крови, что может рассматриваться как сибиреязвенный сепсис, и представляет собой клинику инфекционно-токсического шока. Это тяжёлые нарушения свертывающей и антисвертывающей систем крови, ацидоз, острая почечная недостаточность, падение температуры тела ниже нормы, сильнейшая интоксикация.

Сибиреязвенный карбункул с отеком окружающих тканей Формирование струпа на коже предплечья.

• Обычно карбункул бывает один, но иногда их количество доходит до 10— 20 и более. На месте входных ворот инфекции последовательно развивается пятно, папула, везикула, язва. Безболезненное пятно красновато-синего цвета и диаметром 1 — 3 мм, имеющее сходство со следом от укуса насекомого, через несколько часов переходит в папулу медно-красного цвета. Нарастают зуд и ощущение жжения. Через 12— 24 ч. папула превращается в пузырёк диаметром 2— 3 мм, заполненный жидкостью, которая темнеет и становится кровянистой. При расчёсывании (иногда и самопроизвольно) пузырёк лопается, и на его месте образуется язва с тёмнокоричневым дном, приподнятыми краями и серозногеморрагическим отделяемым. Через сутки язва достигает 8— 15 мм в диаметре. В результате некроза центральная часть язвы через 1— 2 недели превращается в чёрный безболезненный плотный струп, вокруг которого имеется выраженный воспалительный валик красного цвета. Внешне струп напоминает уголёк в пламени, что и послужило поводом для названия этой болезни (Antrax - уголь). Это поражение и получило название карбункула.

Струп при сибирской язве Так выглядит язва примерно на 10 день болезни

• • • Септическая форма сибирской язвы Генерализованная форма может быть как первичной, т. е при заражении алиментарным или аэрогенным путём, так и вторичной в результате возникновения септицемии из-за распространения возбудителя лимфогенным и гематогенным путём. Эта форма характеризуется бурным началом, потрясающим ознобом, резковыраженными симптомами интоксикации, головной болью, рвотой, тахикардией, прогрессирующей гипотензией (снижение системного давления), глухостью сердечных тонов. При заражении аэрогенным путём возникает легочная форма генерализванного течения и, ко всему прочему, характерному для генерализованной формы присоединяются следующие симптомы: удушье, боли в грудной клетке при дыхании, одышка, кашель с кровавой мокротой которая почти сразу приобретает желеобразную консистенцию, ослабление дыхания и укорочение перкуторного звука говорит о развившемся плеврите (воспаление плевральных/легочных листков), на расстоянии выслушиваются разнокалиберные влажные хрипы. При это форме смерть наступает в 90% случаев и в течении 2 -3 дней даже при лечении. При заражении алиментарным путём развивается кишечная форма генерализованного течения, для которой кроме общехарактерных симптомов присущи следующие: с первого дня болезни – режущие боли в нижней части живота, кровавая рвота и частый жидкий стул с примесью крови, быстро развивается парез кишечника и перитонит.

Диагноз и дифференциальный диагноз. • Распознавание сибирской язвы основывается на данных эпидемиологического анамнеза (профессия больного, характер обрабатываемого материала, откуда доставлено сырье, контакт с больными животными и др. ). Учитываются также характерные изменения кожи в области ворот инфекции (расположение на открытых участках кожи, наличие темного струпа, окруженного вторичными пустулами, отеком и гиперемией, анестезия язвы). Следует учитывать, что у привитых все изменения кожи могут быть выражены слабо и напоминать стафилококковые заболевания (фурункул и другие). Лабораторным подтверждением диагноза служит выделение культуры сибиреязвенной палочки и ее идентификация. Для исследования берут содержимое пустулы, везикулы, тканевой выпот из-под струпа.
• При подозрении на легочную форму берут кровь, мокроту, испражнения. При кожных формах гемокультура выделяется редко. Взятие и пересылку материала проводят с соблюдением всех правил работы с особо опасными инфекциями. Для исследования материала (шкуры, шерсть) применяют реакцию термопреципитации (реакция Асколи). Для обнаружения возбудителя используют также иммунофлуоресцентный метод. В качестве вспомогательного метода можно использовать кожноаллергическую пробу со специфическим аллергеном антраксином. • Препарат вводят внутрикожно (0, 1 мл). Результат учитывают через 24 и 48 ч. Положительной считается реакция при наличии гиперемии и инфильтрата свыше 10 мм в диаметре при условии, что реакция не исчезла через 48 ч.

• Дифференцировать необходимо от фурункула, карбункула, рожи, в частности от буллезной формы. Легочную (ингаляционную) форму сибирской язвы дифференцируют от легочной формы чумы, туляремии, мелиоидоза, легионеллеза и тяжелых пневмоний другой этиологии.

Лечение. • Для этиотропного лечения используют антибиотики, а также специфический иммуноглобулин. Чаще всего назначают пенициллин при кожной форме 2 млн-4 млн ЕД/сут парентерально. После исчезновения отека в области язвы можно назначать препараты пенициллина перорально (ампициллин, оксациллин еще в течение 7 -10 дней). При легочной и септической формах пенициллин вводят внутривенно в дозе 16 -20 млн ЕД/сут, при сибиреязвенном менингите такие дозы пенициллина сочетают с 300 -400 мг гидрокортизона. При непереносимости пенициллина при кожной форме сибирской язвы назначают тетрациклин в дозе 0, 5 г 4 раза в день в течение 7 -10 дней. Можно использовать также и эритромицин (по 0, 5 г 4 раза в день 7 -10 сут). В последнее время рекомендуют ципрофлоксацин по 400 мг через 812 ч, а также доксициклин по 200 мг 4 раза в день, а затем по 100 мг 4 раза в день.

• Специфический противосибиреязвенный иммуноглобулин вводят внутримышечно в дозе 20 -80 мл/сут (в зависимости от клинической формы и тяжести болезни) после предварительной десенсибилизации. Вначале для проверки чувствительности к лошадиному белку вводят внутрикожно 0, 1 мл иммуноглобулина, разведенного в 100 раз. При отрицательной пробе через 20 мин вводят подкожно 0, 1 мл разведенного (1: 10) иммуноглобулина и через 1 ч - всю дозу внутримышечно. При положительной внутрикожной реакции от введения иммуноглобулина лучше воздержаться.

Прогноз. • До введения в практику антибиотиков смертность при кожной форме достигала 20%, при современном рано начатом лечении антибиотиками она не превышает 1%. При легочной, кишечной и септической формах прогноз неблагоприятный. Лечение больного сибирской язвой. Алтайский край, 27/08/2012. Фото ИТАР-ТАСС

Вспышка сибирской язвы в Алтайском крае 30. 08. 2012 • в Алтайском крае диагноз «сибирская язва» был подтвержден у четырех человек. По некоторым данным, «население с. Дружба, находившиеся в непосредственно-тесном контакте с животными, получают в настоящее время профилактическое лечение, из них восемь человек с превентивной целью для медицинского наблюдения направлены в инфекционное отделение, в госпиталь. Проводится ряд необходимых лабораторных исследований» . • в селах Дружба и Марушка проводились профилактические и противоэпидемические мероприятия. «В результате медицинских наблюдений, больных среди жителей больше не выявлено. Имеется достаточное количество лекарственных и дезинфицированных препаратов. • За животными Алтайского края ужесточен контроль по предупреждению распространения заболевания. • Представители Алтайского края заявляют, что очаг сибирской язвы локализован полностью. Не смотря на это, мероприятия по санитарно-противоэпидемической профилактике все еще будут проводиться.

Профилактика и мероприятия в очаге. • Выявление и ликвидация очагов инфекции по линии ветеринарной службы. Лицам, подвергающимся опасности заражения сибирской язвой (работникам предприятий по переработке кожевенного сырья и шерсти, мясокомбинатов, ветеринарным работникам, работникам лабораторий, работающим с возбудителем сибирской язвы), проводят профилактические прививки сибиреязвенной живой сухой вакциной (СТИ). Непосредственно перед прививками ампулу с сухой вакциной вскрывают, шприцом вводят в нее 1 мл 30% раствора глицерина (приложен к коробке с вакциной), слегка встряхивают до получения равномерной взвеси. На кожу верхней трети плеча наносят (после предварительной обработки кожи спиртом или эфиром) 2 капли вакцины и делают насечки через каждую каплю. • Больных госпитализируют в отдельную палату, проводят текущую дезинфекцию. Выписывают после полного выздоровления и эпителизации язв. • За лицами, контактировавшими с больными животными, устанавливается медицинское наблюдение в течение 2 нед.

СПАСИБО за внимание!!!
Сибирская язва11.pptx